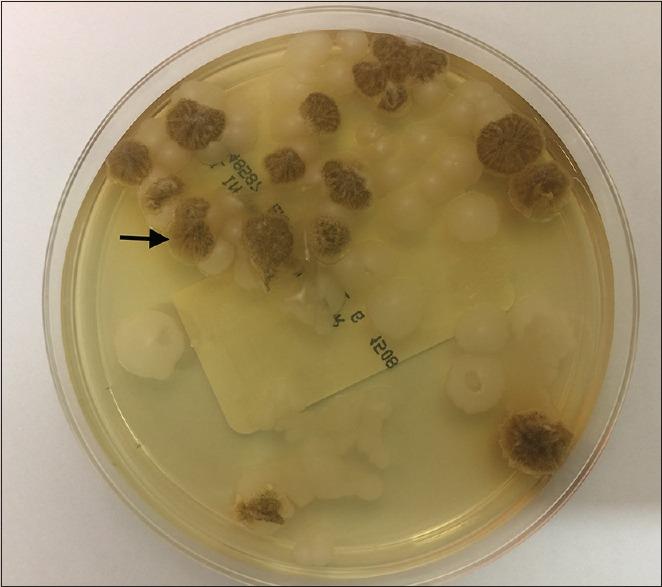

在巴氏涂片检查中:一种极其罕见的发现,可能会被误诊为……
in a Papanicolaou test: An exceedingly rare finding that can be mistaken for .
作者信息
Sharma Ninu, Schwartzman Joseph D, Gutmann Edward J, Marotti Jonathan D, Liu Xiaoying
机构信息
Address: Dartmouth Hitchcock Medical Center, Lebanon, NH, USA.
出版信息
Cytojournal. 2018 Feb 16;15:5. doi: 10.4103/cytojournal.cytojournal_35_17. eCollection 2018.
is a zygomycetes yeast form that is very rarely detected in Papanicolaou (Pap) tests, in which it typically represents an innocuous colonizer. Its morphology closely resembles that of the better known , which can disseminate widely and cause clinically significant disease. We present a case of detected in a cervical liquid-based preparation obtained from a 38-year old healthy woman. Careful cytomorphologic evaluation, in combination with culture and molecular techniques, was utilized to make a diagnosis and prevent the misdiagnosis of .
是一种接合菌酵母形态,在巴氏(Pap)涂片检查中极少被检测到,在该检查中它通常是无害的定植菌。其形态与更为人熟知的[某种菌]非常相似,[那种菌]可广泛播散并引发具有临床意义的疾病。我们报告一例在一名38岁健康女性的宫颈液基制片中检测到[该菌]的病例。通过仔细的细胞形态学评估,结合培养和分子技术来进行诊断并防止对[该菌]的误诊。